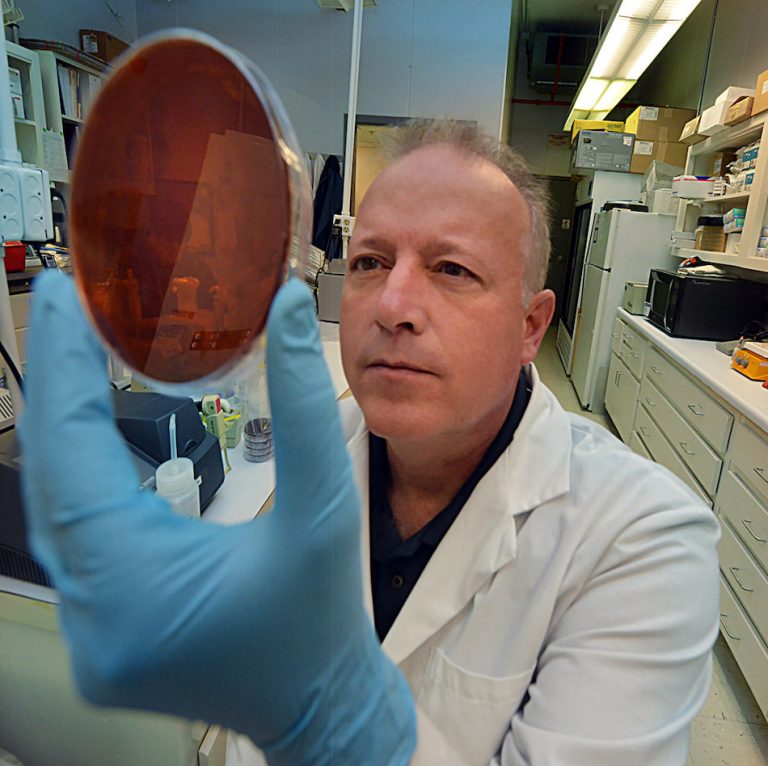

Student Health Services relocating to Health Sciences Building
“This move aligns with our mission to provide life-changing, life-saving care by offering our students the highest standard of care,” says Scott Wallace, PhD.
Augusta University plans to expand its animation program to include an additional 21 faculty members in the Department of Art and Design, which will make it possible to attract about 400 more animation students in the coming years.

“This move aligns with our mission to provide life-changing, life-saving care by offering our students the highest standard of care,” says Scott Wallace, PhD.

“This move aligns with our mission to provide life-changing, life-saving care by offering our students the highest standard of care,” says Scott Wallace, PhD.


“This move aligns with our mission to provide life-changing, life-saving care by offering our students the highest standard of care,” says Scott Wallace, PhD.

TUNE IN






STAY INFORMED
Jag Mobile is a one-stop virtual location for all need-to-know information and a centralized resource for other apps. This will include news and alerts, department updates, emergency information, health resources, student updates and more.
Stay connected and download “Jag Mobile by AU” today!
The annual event was held Sept. 7 on the Summerville Campus.

The book is designed for current instructors of public administration, political science and social science.

Take a trip around the world during the 2018 International Education week!

An MCG lab has been designated to help with patient testing for a trial assessing the effectiveness of targeting cancer-causing gene changes rather than cancer type.

See photos shared by Augusta University and AU Health faculty, staff and students.

Georgia War Veterans Nursing Home will celebrate Veterans Day on Nov. 12.